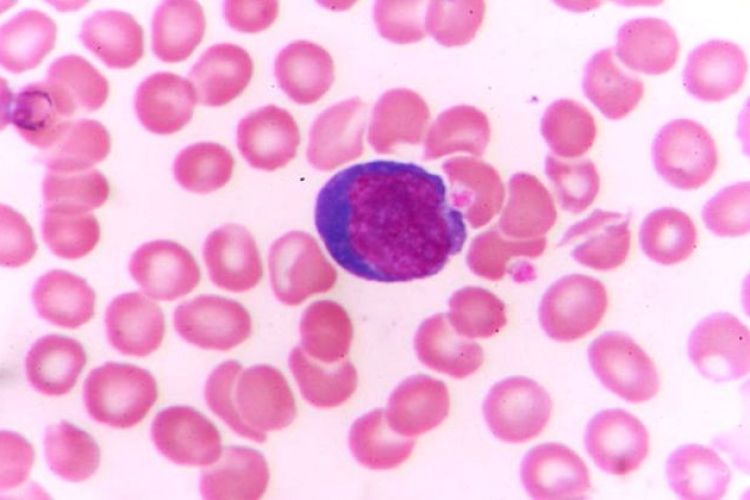
Testünk őrszemei: a gyilkos sejtek

Hírek

2016. Március 13. 12:00, vasárnap | Helyi
Testünk őrszemei: a gyilkos sejtek
Mi ellen harcolnak, és hogyan ölik meg a betolakodókat testünk védelmi rendszerének főszereplői, a falósejtek és az ölősejtek?
Mi ellen harcolnak, és hogyan ölik meg a betolakodókat testünk védelmi rendszerének főszereplői, a falósejtek és az ölősejtek?